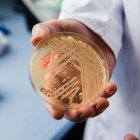
El director del Centro Nacional de Referencia para Infecciones Invasivas por Hongos, Oliver Kurzai, sostiene una placa de Petri que contiene la levadura "Candida auris".

China desvela detalles de la futura estación lunar conjunta con Rusia
Buscar otro planeta para los humanos, estudiar la luna y responder la pregunta de si estamos solos en el universo es el plan de ambos países.

China y Rusia quieren tener una base científica operativa en la Luna para 2035.
Científicos chinos revelaron más detalles acerca de la Estación Internacional de Investigación Lunar (EIIL), un proyecto conjunto entre China y Rusia que servirá para "estudiar la evolución" de la Luna y para "buscar otro planeta apropiado para los humanos".

Ciencia y Tecnología
Bing “mete” más inteligencia artificial y otros clics tecnológicos en América
Nighell Cedeño Salazar
Está previsto que la estación, en cuyo desarrollo trabajan las agencias espaciales de China y Rusia, esté operativa en 2035.
El proyecto tiene entre sus objetivos el estudio de la evolución lunar para construir un módulo estructural detallado del interior de nuestro satélite, declaró en una conferencia el director de la división de exploración lunar y del espacio profundo de la Academia de Ciencias de China, Zou Yongliao, citado por el diario Global Times.
Además, se realizarán desde la futura estación exploraciones para saber más acerca de la formación y la actividad estelar, explicó Zou, que agregó que el proyecto también espera "responder a la pregunta de si estamos solos en el universo".
"La Luna es el campo principal de la exploración espacial", indicó el experto, que agregó que la construcción de la EIIL "es una necesidad".
Desde la base lunar se llevarán a cabo experimentos de ciencia básica como "estudios sobre el crecimiento y el desarrollo de las plantas en el entorno lunar".
Ciencia y Tecnología
Alarma internacional por mortal hongo que se propaga por Estados Unidos
Nighell Cedeño Salazar
Pekín tiene previsto completar la construcción de la estructura básica de la EIIL alrededor de 2028, mediante sus futuras sondas lunares Chang'e-6, -7 y -8, afirmaron recientemente científicos del programa espacial chino.
La estructura básica comprenderá módulos de alunizaje, vehículos exploradores, un sistema de energía, una infraestructura de comunicación y un sistema de sustento a la vida humana.
China anunció el año pasado la aprobación de la cuarta fase de su programa de exploración lunar, que incluye la construcción de esta base de exploración científica en el polo sur del satélite junto con Rusia.
Construir una base en el polo sur de la Luna tendría la ventaja de que los paneles solares que abastecerían de energía a la estación disfrutarían de más horas de sol que en otros lugares del satélite.

Ecuador
Tormenta eléctrica en Guayaquil activa el sistema de alerta de Sismo Detector
Giannella Espinoza
Tras firmar el acuerdo de cooperación con Rusia en 2021, el diseñador jefe del programa de exploración lunar chino, Wu Weiren, declaró que "si el proyecto de la estación de investigación lunar se puede implementar con éxito, China no estará muy lejos de lograr un aterrizaje tripulado en la Luna".
El programa Chang'e (bautizado así en honor a una diosa que según las leyendas chinas vive en la Luna) comenzó con el lanzamiento de una primera sonda en 2007.
En los últimos años, Pekín ha invertido fuertemente en su programa espacial y ha logrado hitos como el alunizaje exitoso de una sonda en la cara oculta de la Luna en enero de 2019, un logro que ningún país había conseguido hasta la fecha.




